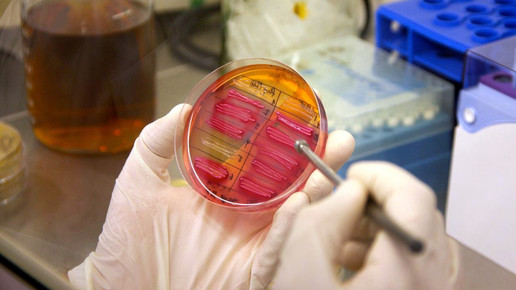
dbu 06 dbu

Umweltstiftung fördert nachhaltige Pharmazie
Laut der Deutschen Bundesstiftung Umwelt (DBU) gelangen zu viele Arzneimittelrückstände in die Umwelt. Seit 2012 unterstützt die Stiftung mit der Förderinitiative „Nachhaltige Pharmazie“ Projekte, die neue ressourcenschonende Herstellungsmethoden besser abbaubarer Wirkstoffe entwickeln. „Es gibt eine ganze Reihe vielversprechender Ansätze, um Umweltbelastungen deutlich zu verringern“, sagt der Pharmazieexperte der DBU, Dr. Maximilian Hempel.
Im Rahmen der Förderinitiative greift die DBU neue Ansätze zur Vermeidung und Verminderung von Arzneimittelrückständen und zur Entwicklung neuer ressourcen- und energieeffizienter sowie umweltfreundlicher Herstellungsverfahren auf.
Bislang sei die Stiftung vor allem aus der Umwelttechnik bekannt, weniger jedoch aus der Pharmatechnik. „Deshalb sind die meisten geförderten Projekte bisher überwiegend im Bereich der Herstellungsverfahren angesiedelt“, sagt Hempel. Diese würden etwa prozessanalytische Technologien entwickeln, um Abfall und Fehlchargen zu vermeiden sowie neue umweltfreundliche Synthese- und Aufreinigungsverfahren.
„Ein wichtiger Ansatz ist aber auch, die Dosierung so zu gestalten, dass die Menge ausgeschiedener Wirkstoffe verringert wird“. Von insgesamt zwölf geförderten Projekten im Bereich nachhaltiger Pharmazie erforscht bislang eines einen entsprechenden Ansatz: Die Universität Lüneburg erhält 460.000 Euro von der DBU für ein Forschungsprojekt zur Entwicklung eines umweltfreundlichen Antibiotikums.
Die Wissenschaftler versuchen, eine besser abbaubare Alternative zu Ciprofloxacin zu entwickeln. „Ciprofloxacin gehört zu der wichtigen Gruppe der vielverschriebenen Fluorchinolonen“, sagt Hempel. Es werde breit eingesetzt, sei im Gegensatz zu anderen Antibiotika wie Penicillin aber besonders stabil und schwer abbaubar sowie bereits bei geringer Konzentration sehr wirksam.
Nach der Technik „benign by design“ nutzen die Wissenschaftler Rechenmodelle, um herauszufinden, wie ein Molekül aussehen muss, damit es bei gleicher Wirksamkeit besser abgebaut wird: „Auf der Basis von Voruntersuchungen zur Abbaubarkeit wollen wir zunächst die bestehende Wirksubstanz analysieren und sie mithilfe von Computermodellen vielfach verändern“, sagt Professor Dr. Klaus Kümmerer vom Institut für Nachhaltige Chemie und Umweltchemie der Universität Lüneburg.
„Die dann entstandenen Varianten wollen wir in theoretischen Rechenmodellen auf eine verbesserte biologische Abbaubarkeit und geringere toxikologische Effekte prüfen“, so Kümmerer. Anschließend sollen die aussichtsreichsten Kandidaten im Labor chemisch-synthetisch hergestellt und im Reagenzglas mit Blick auf antibiotische Wirksamkeit gegenüber resistenten Keimen, biologische Abbaubarkeit und mögliche Nebenwirkungen getestet werden.
Lösungsansätze sind der DBU zufolge außerdem Arzneimittel, die bei gleicher Wirksamkeit bereits im Körper möglichst vollständig abgebaut und nicht mehr ausgeschieden würden. Bei der jüngsten Ausschreibung suchte die Förderinitiative auch nach solchen Projekten, etwa Bestrebungen zur Verlustminderung pharmakologisch aktiver Substanzen durch Änderung der Formulierung, Applikations- oder Darreichungsform.
Bis Januar seien mehrere entsprechende Projektanträge eingegangen, die den Ansatz der Mikronisierung verfolgten, so die DBU. Dabei wird der Wirkstoff verkleinert, das Verhältnis von Oberfläche zu Volumen wächst. Dadurch wächst auch die Aufnahmerate, also die Bioverfügbarkeit. Demzufolge muss weniger eingenommen werden und es wird weniger ausgeschieden.
Ein weiterer Ansatz ist laut Umweltstiftung das „drug targeting“, das selektive Anreichern eines Arzneistoffs am gewünschten Wirkort nach systemischem Verabreichen eines Medikaments. Dazu gebe es aber noch keine geförderten Projekte. Auch mit personalisierter Medizin und verbesserter Diagnostik lasse sich die Ausscheiderate von Wirkstoffen deutlich reduzieren.
Insgesamt hat die DBU rund 8800 Projekte gefördert, jedes Jahr kämen im Schnitt 400 dazu. Gefördert werden etwa kleine und mittlere Unternehmen und Forschungseinrichtungen. Zudem wurden in den vergangenen 20 Jahren 50 bis 60 Promotionsstipendien vergeben.
Nicht nur Antibiotika, sondern Arzneimittel generell könnten ungewollte Auswirkungen auf die Umwelt haben, kritisiert die DBU. Bestimmte Antiepileptika, etwa Carbamazepin, und Betablocker wie Metoprolol gegen Bluthochdruck würden die Organe von Fischen schädigen: Ethinylestradiol verändere die Geschlechtsmerkmale bei Fischen, Oxazepam habe Einfluss auf das Verhalten von Barschen.
Etwa die Hälfte der 2300 in Deutschland verwendeten Wirkstoffe gilt der Stifung zufolge als umweltrelevant. Seit Mitte der 1980er Jahre würden vermehrt Arzneimittel in der Umwelt nachgewiesen. In mehr als 70 Ländern der Welt fänden sich in Umweltproben mehr als 500 verschiedene Arzneimittel und deren Metabolite. Restwirkstoffe gelangten in Oberflächengewässer, Grund- und Trinkwasser, Böden oder Gülle.
Bisher seien nur vereinzelt Spuren der Mikroschadstoffe im Trinkwasser nachgewiesen worden, so die DBU. Eine unmittelbare Gefahr für die menschliche Gesundheit bestehe nach derzeitigen Erkenntnissen nicht, Studien zu Langzeitwirkungen gebe es aber nicht.

APOTHEKE ADHOC Debatte